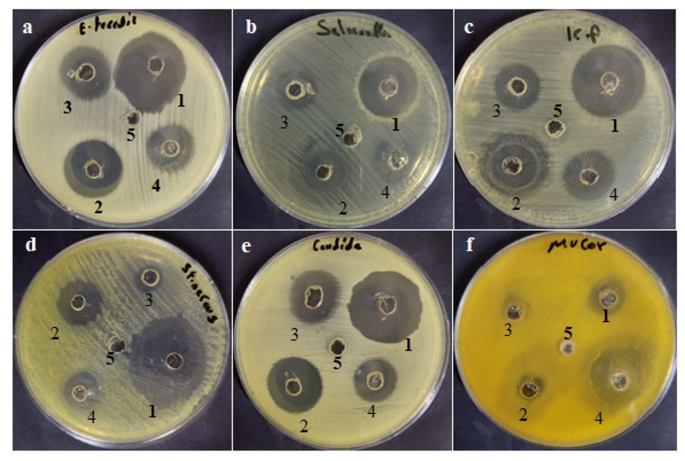
Fig. 4

Abstract
Pathogenic microorganisms, ovarian cancer, and inflammation represent significant health challenges, as infections can disrupt the vaginal microbiome, chronic inflammation contributes to cancer progression. This study explored the enhancement of the therapeutic efficacy of vaginal wash (VW) incorporate chitosan nanoparticles (Chit) (VW + Chit) to create a multifunctional formulation targeting microbial infections, inflammation, and ovarian cancer. Gas Chromatography–Mass Spectrometry analysis identified 42 chemical constituents in the vaginal wash, including bioactive alcohols, esters, ethers, and fatty acids, with major components including 1,2-benzenedicarboxylic acid, diethyl ester (24.83%) and Diethylene glycol monododecyl ether (7.10%). Transmission electron microscopy imaging revealed that VW + Chit nanoparticles exhibited improved morphology, reduced agglomeration, and increased particle size (~ 41 nm), indicating successful interaction and encapsulation. Fourier transform infrared spectroscopy confirmed strong intermolecular bonding between chitosan and vaginal wash components, suggesting enhanced structural stability. Antimicrobial testing showed that VW + Chit achieved significantly greater inhibition zones and lower MIC/MBC/MFC values across multiple pathogens, particularly Staphylococcus aureus, Enterococcus faecalis, and Candida albicans, outperforming both its individual components and standard antibiotics. The formulation VW + Chit also demonstrated potent anti-inflammatory activity, with COX-1 and COX-2 inhibition reaching 92.9% and 94.3%, with lowest IC₅₀ values 20.92 ± 0.1 and 9.23 ± 0.1 µg/mL, respectively compared to IC₅₀ values of utilize VW (47.52 ± 0.4 and 43.73 ± 0.1 µg/mL) and Chit alone (27.39 ± 0.1 and 21.67 ± 0.1 µg/mL), respectively. Cytotoxicity assays on SKOV3 ovarian cancer cells revealed that VW + Chit exerted the strongest dose-dependent cytotoxic effect, with the lowest IC₅₀ (147.3 µg/mL) and significant G1 phase cell cycle arrest, indicating antiproliferative potential. In conclusion, the VW + Chit composite shows enhanced antimicrobial, anti-inflammatory, and anticancer activities, highlighting its potential as a novel therapeutic formulation. These findings warrant further investigation through formulation refinement and in vivo studies to validate its clinical applicability for gynecological use.
Similar content being viewed by others
Introduction
The increasing occurrence of multidrug-resistant pathogens, gynecological infections, and cancers affecting the female reproductive system, especially ovarian cancer, presents a significant challenge to women’s health globally1. Infections in the vagina caused by bacteria, fungi, and viruses not only lead to discomfort and reproductive issues but also heighten the risk of severe conditions like pelvic inflammatory disease and gynecological cancers2. Furthermore, inflammation within the vaginal and reproductive tract acts as a crucial pathological factor in these conditions, frequently complicating treatment efforts3. Among gynecological malignancies, ovarian cancer has the highest mortality rate4.
Vaginal washes are frequently utilized for hygiene and infection management; however, their traditional formulations frequently demonstrate limited effectiveness due to inadequate retention, low bioavailability, and a lack of ability to penetrate mucosal barriers5. This constraint underscores the need for the creation of advanced delivery systems that can improve therapeutic results while reducing side effects.
Nanoparticles and nanocomposites have emerged as groundbreaking instruments in the realm of healthcare and biomedical sciences6,7,8. Their distinctive physicochemical characteristics, including a high surface area and adjustable size, facilitate targeted and controlled drug delivery9. These nanomaterials improve the bioavailability and therapeutic effectiveness of medications while minimizing side effects10,11. Antimicrobial nanocomposites provide powerful solutions against multidrug-resistant pathogens12,13. In the context of cancer treatment, nanoparticles allow for site-specific drug delivery and photothermal therapy. Nanocarriers are also utilized in gene delivery and vaccine development. Overall, nanotechnology presents innovative, efficient, and safer solutions in contemporary medicine14. Chitosan, a biopolymer that is naturally sourced from chitin, has attracted considerable interest due to its distinctive characteristics, including biodegradability, mucoadhesiveness, and inherent antimicrobial properties. When developed into nanoparticles, chitosan demonstrates improved penetration and extended retention within mucosal tissues15. Additionally, chitosan nanoparticles present a promising opportunity as vehicles for the delivery of bioactive compounds, enhancing antimicrobial, anti-inflammatory, and anticancer effects at specific locations16. Despite the established antimicrobial and biocompatible characteristics of chitosan, there exists a considerable research gap regarding its integration into vaginal wash formulations designed to concurrently address infectious agents, inflammation, and cancerous cells—especially in relation to ovarian cancer. Present studies infrequently combine these three therapeutic elements into a unified nanosystem. This research aims to create and assess a vaginal wash fortified with chitosan nanoparticles to enhance its effectiveness against pathogenic microorganisms, mitigate inflammatory responses, and demonstrate potential anticancer properties, particularly against ovarian cancer cells. By tackling the existing shortcomings of vaginal washes, this formulation may provide a multi-targeted, safe, and efficient therapeutic solution for women’s reproductive health.
Materials and methods
Material used
Vaginal wash (Brett—Intimate Feminine Wash is a gentle and effective solution for women’s intimate hygiene) Containing Panthenol, Stearyl alcohol, Glycerin, Chamomile extract, Tea tree oil, Almond oil, Cactus extract, Sage extract, Vitamin E, Citric acid, and Peppermint [a commercially available product used and easily accessible]. It manufactured by: Arab Company for Pharmaceuticals and Cosmetics Selsan Pharma—licensed by the Egyptian Ministry of Health and Population, Registration No. at the Ministry of Health: 2546/2020. Chitosan nanoparticles (Chit NPs) were purchased from Primex, Siglufjordur, Iceland. Other chemicals including solvents, reagents, and bacterial/fungal growth media were attained from Sigma-Aldrich (St. Louis, MS, USA).
GC-MS method for analysis of vaginal wash sample
The chemical composition of the vaginal wash sample was analyzed using Gas Chromatography–Mass Spectrometry (GC-MS) with an ISQ 7000 single quadrupole mass spectrometer (Thermo Scientific). The following instrumental parameters and conditions were applied for the analysis: Sample injection and GC conditions: Injection volume: 1.00 µL; Injection mode: Splitless (front inlet), Inlet Temperature: 250 °C, Carrier Gas: Helium with flow rate: 1.5 mL/min, Splitless Time: 1.00 min. Oven Temperature Program: Initial temperature of 45.0 °C held for 1.00 min, Ramp 1: Increase at 3.0 °C/min to 200.0 °C; hold for 3.00 min; Ramp 2: Increase at 3.0 °C/min to 280.0 °C; hold for 10.00 min with maximum temperature 280.0 °C. MS Detection Conditions including ionization mode: Electron Ionization (EI) including ion source temperature: 250 °C; transfer line temperature: 240 °C; Mass range: 50–1000 amu; scan time: 0.2 s. The acquired spectrum is compared to spectral libraries (e.g., NIST, Wiley)17. The software provides a match score indicating similarity between the unknown and library entries.
Preparation of VW + Chi
First, chitosan nanoparticles are synthesized—most commonly through the ionic gelation method, where chitosan is dissolved in an acidic solution and crosslinked with sodium tripolyphosphate (TPP). The drug loading was done by mixing the vaginal wash with the chitosan solution before crosslinking). Once formed, the nanoparticles are purified by centrifugation at 10,000 rpm for 10 min to remove unbound drug or reagents. The resulting formulation is then characterized18.
Characterization of VW, Chit, and VW + Chit by FTIR and TEM
To explore the chemical functional groups involved in the stabilization of the vaginal wash (VW), chitosan nanoparticles (Chit), and the combined formulation (VW + Chit), Fourier Transform Infrared Spectroscopy (FTIR) (FT-IR; FTIR 8400 S, Shimadzu, Tokyo, Japan) analysis was conducted. Samples were scanned over the spectral range of 400–4000 cm⁻¹ to identify characteristic absorption bands indicative of functional moieties exist in each formulation. The morphological features and particle size of the Chit and VW + Chit formulations were analyzed via Transmission Electron Microscopy (TEM) (JEOL JEM-1200 system, JEOL, Tokyo, Japan). Prior to imaging, each compound dispersion was deposited onto a carbon-coated copper grid. The samples were left to stand until complete adsorption onto the grid surface occurred, after which they were examined under the microscope to evaluate the shape and average size of the compounds19.
Method for antimicrobial efficacy testing via agar well diffusion assay
The agar well diffusion method was used to assess the antibacterial activity of three treatments against specific pathogenic microorganisms: vaginal wash (VW), chitosan nanoparticles (Chit), and vaginal wash doped with chitosan nanoparticles (VW + Chit). Enterococcus faecalis (ATCC 29212), Staphylococcus aureus (ATCC 6538), Klebsiella pneumoniae (ATCC 13883), Salmonella typhi (ATCC 6539), Candida albicans (ATCC 10221), Mucor circinelloides (AUMMC 11656) were among the strains that were tested. Bacterial strains were cultivated on Mueller-Hinton Agar (MHA), while fungal strains were grown on Sabouraud Dextrose Agar (SDA), and both were incubated at 37 °C for bacteria and at 28–30 °C for fungi for durations of 24 h for C. albicans and 72 h for M. circinelloides. Colonies were suspended in sterile saline and adjusted to the 0.5 McFarland standard, which corresponds to approximately 1.5 × 10⁸ CFU/mL for bacteria and around 1 × 10⁶ CFU/mL for yeast and mold. Sterile MHA plates for bacteria and SDA plates for fungi were prepared. Each plate was evenly inoculated with 100 µL of the appropriate microbial suspension using a sterile cotton swab. Following the absorption of the inoculum, wells with a diameter of 6 mm were created in the agar using a sterile cork borer. Each well was subsequently filled with 100 µL of the corresponding treatment solution: VW (vaginal wash), Chit (chitosan nanoparticles), and VW + Chit. The standard compound (control) comprises ciprofloxacin (targeting bacteria) and fluconazole (targeting fungi) (DMSO 0.2% (V/V) was use as a negative control). The plates were permitted to rest for 1 h at 5 °C for pre-diffusion, followed by incubation at 37 °C (for bacteria) and 28–30 °C (for fungi) for 24 h (for C. albicans) and 72 h (for M. circinelloides). The antimicrobial efficacy was assessed by measuring the diameter of the clear inhibition zones (in mm) surrounding each well with a ruler20.
Method for determining minimum inhibitory concentration (MIC) and minimum bactericidal concentration (MBC) minimum fungicidal concentration (MFC) of VW, Chit, and VW + Chit
The antimicrobial efficacy of vaginal wash (VW), chitosan nanoparticles (Chit), and vaginal wash doped with chitosan nanoparticles (VW + Chit) was evaluated by estimating the minimum inhibitory concentration (MIC), minimum bactericidal concentration (MBC), and MFC using the broth microdilution method21,22. Each treatment (VW, Chit, and VW + Chit) was serially diluted in sterile 96-well microtiter plates using MHB. Each well contained 0.1 mL of the prepared dilution. A standardized bacterial inoculum was prepared by adjusting the microbial suspension to approximately 2 × 10⁸ CFU/mL, corresponding to a 0.5 McFarland standard. Within 15 min of preparation, 0.1 mL of the inoculum was added to each well, resulting in a final bacterial concentration of 1 × 10⁵ CFU/mL per well. The plates were incubated aerobically at 37 °C for 20 h. Bacterial growth was assessed by measuring optical density at 600 nm (OD₆₀₀). The MIC was defined as the lowest concentration of the treatment that completely inhibited visible microbial growth, as indicated by the absence of turbidity and minimal OD readings. To determine the MBC, aliquots (10 µL) from wells that showed no visible growth were subcultured on fresh nutrient agar plates. These plates were incubated for 48 h at 35 °C. The MBC was identified as the lowest concentration at which a 99.9% reduction in colony-forming units (CFU/mL) was observed compared to the positive growth control. Positive control wells (inoculated with bacteria but untreated) and negative control wells (media only) were included to validate the sterility and bacterial viability. MFC was assessed using the broth microdilution technique, adhering to the guidelines set forth by the Clinical and Laboratory Standards Institute (CLSI) with minor adjustments. Fungal colonies were subcultured on SDA, then suspended in sterile normal saline and calibrated to approximately 1 × 106 CFU/mL utilizing a spectrophotometer or the 0.5 McFarland standard. Serial two-fold dilutions of the samples under investigation were prepared in SDB within sterile 96-well microtiter plates. Each well contained 100 µL of the corresponding dilution. Subsequently, 100 µL of the fungal inoculum was introduced into each well to achieve a final concentration of approximately 5 × 10⁵ CFU/mL. The positive control wells included fungal inoculum without any treatment, while the negative control wells contained only broth to ensure sterility. The plates were incubated at a temperature range of 28–30 °C for a duration of 48 h. Following the incubation period, the MIC was noted as the lowest concentration that exhibited no visible fungal growth (absence of turbidity). To ascertain the MFC, 10 µL from each clear (growth-inhibited) well was subcultured onto fresh SDA plates and incubated at 28–30 °C for an additional 48 h. The MFC was defined as the lowest concentration of the treatment at which ≥ 99.9% of the initial fungal population was eradicated, as indicated by the lack of visible fungal colonies on the agar.
In vitro cyclooxygenase (COX-1 and COX-2) Inhibition assays
To assess the inhibitory effects of the test compounds on the cyclooxygenase-1 (COX-1) enzyme, a commercial COX-1 inhibitor screening kit (Biovision, Cat. No. K548, USA) was utilized following the protocol established by the supplier. Each test formulation—VW, Chit, and VW + Chit—was dissolved in dimethyl sulfoxide (DMSO), and serial dilutions were created to achieve final concentrations ranging from 0.5 to 1000 µg/mL in a total assay volume of 1 mL. A control group containing 1% DMSO (vehicle) and a positive control (celecoxib) were included for comparative purposes. All samples were analyzed at various concentrations. In a similar manner, the capacity of the test samples to inhibit cyclooxygenase-2 (COX-2) enzyme activity was evaluated using a specific COX-2 screening assay kit (Biovision, Cat. No. K547, USA), adhering to the manufacturer’s guidelines. Samples were prepared in DMSO and tested at concentrations identical to those employed in the COX-1 assay (0.5–1000 µg/mL, final volume 1 mL). The vehicle control (DMSO 0.2% (V/V) was use as a negative control) and celecoxib (reference inhibitor) served as negative and positive controls, respectively23. The extent of enzyme inhibition was quantified, and the half-maximal inhibitory concentration (IC₅₀) values were calculated using nonlinear regression analysis with GraphPad PRISM software.
Cytotoxicity evaluation of VW, Chit, and VW + Chit on SKOV3 cells using MTT assay
Two cell lines including SKOV3 (human ovarian carcinoma, ATCC® HTB-77™) and WI38 (normal human fetal lung fibroblast, ATCC® CCL-75™) cell lines were obtained from the American Type Culture Collection (ATCC, Manassas, VA, USA) to evaluate the cytotoxicity of VW, Chit, and VW + Chit. The viability of SKOV3 cells was evaluated using a modified MTT colorimetric assay protocol compared to WI38 cell. Cell lines were grown in complete RPMI-1640 medium enriched with 10% fetal bovine serum and suitable antibiotics. For the assay, cells were plated at a density of 1 × 10⁵ cells/mL in 96-well tissue culture plates (100 µL per well) and incubated for 24 h at 37 °C in a humidified environment with 5% CO₂ to facilitate the development of a uniform monolayer. Following incubation, the growth medium was carefully removed, and the cells were gently washed twice with serum-free medium to eliminate any residual serum components. Fresh serial two-fold dilutions of each test formulation (VW, Chit, and VW + Chit) were prepared in RPMI containing 2% serum to support cell metabolism. A volume of 100 µL from each dilution was added to the corresponding wells. Control wells were treated with only maintenance medium without any additional treatment. The plates were once more incubated under standard conditions for a duration of 24 h. Following this exposure period, MTT reagent (prepared at a concentration of 5 mg/mL in phosphate-buffered saline) was introduced to each well at a volume of 20 µL. The plates were gently agitated for 5 min at 150 rpm to ensure thorough mixing, and subsequently incubated for 4 h at 37 °C to facilitate the reduction of MTT to formazan crystals by mitochondrial enzymes in viable cells. Upon completion of the incubation, the media were carefully discarded, and the formed formazan crystals were dissolved by adding 200 µL of DMSO to each well (DMSO 0.2% (V/V) was use as a negative control). The plates were shaken again for 5 min at 150 rpm to guarantee complete solubilization of the formazan. Absorbance was then recorded at 560 nm using a microplate reader, with background correction performed at 620 nm. The absorbance values obtained were directly proportional to the quantity of viable cells24. Cell morphology and the integrity of the monolayer were assessed using an inverted microscope.
Analysis of cell cycle analysis
Cell cycle distribution was assessed using flow cytometry following propidium iodide (PI) staining. SKOV3 cells were seeded at a concentration of 2 × 10⁵ cells and treated with the combination of vaginal wash and chitosan nanoparticles (VW + Chit). After treatment, cells were fixed in 70% ethanol at 4 °C and incubated overnight. Subsequently, the cells were centrifuged for 10 min at 1000 rpm, washed with PBS, and resuspended in PBS (250 µL). RNase was added, and the suspension was incubated for 20 min to remove RNA. Finally, the cells were stained with PI, and cell cycle phases were analyzed by flow cytometry25.
Statistical analysis
All experiments have repeated three times and analysis was done by one-way ANOVA with post-hoc test where P ≤ 0.05 considered as significant difference.
Result and discussion
The GC-MS analysis of Brett vaginal wash revealed a complex mixture of 42 chemical constituents, varying in retention time (RT), molecular formula, and relative abundance (area %) (Fig. 1; Table 1). The greatest abundant constituent was 1,2-Benzenedicarboxylic acid, diethyl ester (24.83%, RT = 35.59), followed by Diethylene glycol monododecyl ether (7.10%, RT = 49.36), Triethylene glycol monododecyl ether (6.19%, RT = 58.04), and 1-Dodecanol (4.94%, RT = 31.36). Other notable constituents comprise 3,7-Dimethylocta-1,6-dien-3-ol (1.53%), 1-Hexadecanol (1.66%), and Methyl (3-oxo-2-pentylcyclopentyl) acetate (1.35%). Numerous composites seemed in lower concentrations (below 1%), such as Levomenthol (0.12%), Benzoic acid (0.06%), n-Hexadecanoic acid (0.23%), and 9-Octadecenoic acid (Z) (0.24%). The chemical classes identified include alcohols, esters, ethers, fatty acids, aromatic compounds, and heterocyclic derivatives. Retention times ranged from 14.61 to 82.49 min, indicating a wide range of volatility and polarity among the constituents. These outcomes indicate the occurrence of various functional compounds potentially contributing to the physical, chemical, and biological properties of the vaginal wash. GC-MS profiling of Brett Intimate Feminine Wash—a product formulated with different ingredients—revealed the presence of alcohols, esters, ethers, fatty acids, and aromatics, highlighting the formulation’s diverse chemical nature. The GC–MS analysis revealed also the presence of synthetic constituents such as phthalates and glycol ethers. The detected synthetic compounds, such as phthalates and glycol ethers, are common excipients or stabilizers used in cosmetic and pharmaceutical preparations to enhance solubility, viscosity, or preservation. According to Singh26, natural constituents such as chamomile, tea tree oil (TTO), and peppermint are extensively involved in modern feminine washes because their soothing, antimicrobial, and anti-inflammatory properties. The GC-MS analysis of tea tree oil identified 34 compounds, with monoterpenes, alcohols, and sesquiterpene hydrocarbons being the predominant chemical classes27.
Chromatogram analysis of Brett vaginal wash via GC-MS analysis.
TEM images reflected that the chitosan nanoparticles were spherical to semi-spherical, irregular and aggregated, forming dense clusters with the mean size 29.31 nm. On the other hand, VW + Chit were appeared more distinct and well-dispersed, with less agglomeration and mean size 41.16 nm (Fig. 2). There was evidence of increased particle size or coating, likely resulting from interaction with components in the vaginal wash. Moreover, some particles exhibited halo-like structures, suggested the presence of organic matrix or encapsulation around chitosan particles. The difference in particle dispersion, clarity, and morphology among the chitosan nanoparticles and VW + Chit suggested successful functional interaction among chitosan and vaginal wash constituents. The VW + Chit seemed with more uniform and stabilize nanostructures, probable due to encapsulation or surface adsorption of bioactive constituents of vaginal wash onto the chitosan surface. Nayak et al.28 mentioned that chitosan has garnered significant attention in vaginal drug delivery systems due to its distinctive chemical, physical, and pharmaceutical properties. Its structure, which contains hydroxyl and free amino groups, enables straightforward derivatization under slight conditions to suit specific utilization needs. Additionally, a variety of chitosan-based nanopharmaceuticals—including liposomes, nanoparticles, nanogels, nanofibers, nanofilms, and micelles—have been extensively explored to enhance the therapeutic efficacy of vaginal formulations.
TEM images of Chitosan nanoparticles and Chitosan nanoparticles incorporate vaginal wash (A) Chitosan nanoparticles; (B) Chitosan nanoparticles with vaginal wash.
FTIR spectra of Chit, VW, and VW + Chit were recorded in Fig. 3. The peak at 3442–3443 cm⁻¹ indication the existing O–H or N–H stretching of both chitosan and VW. C–H symmetric and asymmetric stretching were appearwd at 2924 and 2854 cm⁻¹ in VW only. Characteristic weak peak in chitosan Possibly overtone or H-bonded groups was detected at 2623 cm⁻¹ in Chit. C ≡ C or C ≡ N stretching at 2076 cm⁻¹ in Chit and VW + Chit—may suggest nitrile-like groups or structural interactions. Slight shift was seen across spectra indicates interaction (e.g., hydrogen bonding or complexation) between VW and Chit as indicated via C = O or N–H bending (amide I) at 1633–1636 cm⁻¹. The peak at range 1276–1277 cm⁻¹ may reflect the presence of C–N stretching or C–O (polysaccharide backbone) in Chit and VW + Chit—chitosan fingerprint, as illustrated by29. The Shifts in region at bands at 693 cm⁻¹ for Chit, 539 cm⁻¹ for VW + Chit, and 515 cm⁻¹ for VW indicate new interactions or structural changes in the composite formulation. C–H bending and COO⁻ symmetric stretch at 1466, 1392, and 1394 cm⁻¹ were recorded in VW and Chit, retained in VW + Chit—recommends preserved carboxyl or methyl groups. The slight shifts in peak positions, especially around 3443, 1636, and 1394 cm⁻¹, and the disappearance or weakening of some VW -specific peaks (e.g., 1247 cm⁻¹) in the combined spectrum suggest strong intermolecular interactions, likely hydrogen bonding or electrostatic interactions between chitosan and VW components. The characteristic bands of chitosan (e.g., 1277, 1392, 1635 cm⁻¹) remain visible in the VW + Chit spectrum, indicating that chitosan maintains its structural integrity within the formulation. Changes in the 500–700 cm⁻¹ region (e.g., emergence of a new peak at 539 cm⁻¹ in VW + Chit) suggested new bond formation or complexation, confirming successful combination of VW and Chit.
FTIR spectra of Chit, vaginal wash (VW), and Chitosan nanoparticles incorporate vaginal wash (VW + Chit).
Figure 4 presents the antimicrobial efficacy of three treatments—VW, Chit, and VW + Chit—against various microbial strains. An antibiotic control group is also involved for comparison. For all tested microbes (except M. circinelloides), VW + Chit exhibited the largest zones of inhibition, showing superior antimicrobial action compared to VW, Chit alone, and even the antibiotic control. For example, S. aureus showed a 35 ± 0.2 mm inhibition zone with VW + Chit, compared to 20 ± 0.1 mm (VW), 11 ± 0.2 mm (Chit), and 15 ± 0.1 mm (control) (Table 2). VW alone consistently outperformed Chit alone across all tested strains, highlighting that the vaginal wash possesses notable intrinsic antimicrobial activity. This was especially notable against E. faecalis (VW: 24 ± 0.2 mm vs. Chit: 20 ± 0.4 mm) and C. albicans (VW: 24 ± 0.4 mm vs. Chit: 18 ± 0.1 mm). Remarkably, in most cases, VW + Chit showed stronger inhibition than the standard antibiotic control, particularly against Gram-positive bacteria including S. aureus and E. faecalis, as well as the fungus C. albicans. Gram-negative bacteria including K. pneumoniae and S. typhi were moderately sensitive to VW + Chit, showing inhibition zones of 27 ± 0.5 mm and 23 ± 0.4 mm, respectively. However, E. faecalis and S. aureus showed greater sensitivity to VW + Chit (29–35 mm), which may suggest greater susceptibility of Gram-positive strains to this combination. VW + Chit being more effective against C. albicans (31 ± 0.2 mm), though it was less effective against M. circinelloides (13 ± 0.5 mm) compared to the control. Numerous mechanisms have been suggested to explain the antimicrobial activity of chitosan as well as its derivatives. The greatest widely accepted theory is that chitosan disrupts the integrity of the microbial cell membrane, influencing its permeability. This disruption hinders the exchange of gases and nutrients, leading to cellular malfunction. Additionally, chitosan may penetrate the cell, interfering with the synthesis of vital biomolecules such as RNA and DNA, ultimately resulting in cell death30. The mentioned constituents of vaginal wash in our investigation play a critical role in the biological activities, where in a recent investigation29, oral pathogens including Streptococcus sanguinis and Aggregatibacter actinomycetemcomitans were inhibited by TTO. Also, in the same study chitosan exhibited antimicrobial activities towards oral pathogens. Moreover, synergistic effect was observed using mixture of TTO and chitosan. In another study, the formulation of poly(ε-caprolactone) nanocapsules—TTO—Azithromycin coated with chitosan showed a promising inhibition of numerous bacteria31,32. In previous study, the antifungal potential of TTO was recorded against dermatophyte fungus Trichophyton equinum33. The findings of Li et al.34 highlight the potent broad-spectrum antimicrobial activity of TTO, demonstrating its effectiveness against both bacterial (S. aureus and Escherichia coli) and fungal (Aspergillus niger and C. albicans) pathogens. While A. niger conidia showed some resistance, the overall antimicrobial efficacy increased with higher TTO concentrations, as evidenced by prolonged lag phases and enhanced cell killing rates. TEM further confirmed that TTO disrupts microbial structures by penetrating cell walls and membranes, suggesting its potential as a natural antimicrobial agent through multiple cellular targets. According to Ibrahim et al.35, chitosan nanoparticles demonstrate significant clinical potential in treating vulvovaginal candidiasis, especially in combating the increasing challenge of antifungal resistance and recurrence. Their effectiveness is primarily due to their positive surface charge, which promotes strong interactions with negatively charged microbial cell membranes—leading to membrane disruption, increased permeability, and improved antifungal action. Moreover, when formulated with oleic acid and natural actives like plant essential oil, these nanoparticles deliver enhanced antimicrobial, anti-inflammatory, and immunomodulatory effects, further strengthening their therapeutic value.
Clear zones caused by (VW + Chit) (1), VW (2), Chit (3), standrd drug antibiotic/antifungal (4), and negative control(5) using E. faecalis (a), S. typhi (b), K. pneumonia (c), S. aureus (d), C. albicans (e), and M. circinelloid (f).
Across all tested microbes, VW + Chit consistently shows the lowest MIC and MBC/MFC values, indicating superior antimicrobial and antifungal potency. S. aureus: MIC = 7.8 µg/mL (VW + Chit) vs. 125 µg/mL (Chit), 31.25 µg/mL (VW), C. albicans: MFC = 15.62 µg/mL (VW + Chit) vs. 125 µg/mL (Chit), 62.5 µg/mL (VW) (Table 3). This suggests a synergistic effect when Chit are combined with the VW. Chit alone has relatively higher MIC and MBC values, especially against S. aureus (MIC = 125 µg/mL; MBC = 250 µg/mL), M. circinelloides (MIC = 125 µg/mL; MFC = 250 µg/mL). This indicates that Chit on its own is less effective, particularly against fungi and Gram-positive bacteria. VW alone generally performs better than Chit alone, though not as effectively as VW + Chit. For instance, K. pneumoniae: MIC = 31.25 µg/mL (VW) vs. 62.5 µg/mL (Chit), E. faecalis: MBC = 31.25 µg/mL (VW) vs. 62.5 µg/mL (Chit). This implies that the constituents of the vaginal wash contribute significantly to antimicrobial activity. Antimicrobial evaluations reflected that the optimized Metronidazole-loaded chitosan nanoparticle formulation exhibited improved effectiveness against bacterial vaginosis pathogens, achieving a MIC of 0.9 ± 0.1 µg/mL—superior to that of Metronidazole alone36.
By measuring the inhibition of the COX-1 and COX-2 enzymes at different doses, the data in Table 4 shows the anti-inflammatory potential of three treatments: VW, Chit, and VW + Chit. Both COX-1 and COX-2 inhibition increased in a dose-dependent manner in all three formulations. Nevertheless, at all concentrations, the VW + Chit combo continuously performed better than VW and Chit alone. Chit and VW + Chit exhibit statistically greater inhibition than VW alone at low concentrations (e.g., 0.5–2.0 µg/mL). VW + Chit produces noticeably better inhibition (e.g., 92.9% at 1000 µg/mL) at larger doses (≥ 31.25 µg/mL) with lower IC₅₀: IC₅₀ VW = 47.52 µg/mL, Chit = 27.39 µg/mL, and VW + Chit = 20.92 µg/mL. COX-2 is the primary target for anti-inflammatory drugs (because of fewer gastrointestinal side effects than COX-1 inhibition). The VW + Chit formulation shows the highest inhibition (e.g., 94.3% at 1000 µg/mL) and lowest IC₅₀: VW IC₅₀ = 43.73 µg/mL, Chit IC₅₀ = 21.67 µg/mL, and VW + Chit IC₅₀ = 9.23 µg/mL. This suggests strong synergistic effects between VW and Chit in targeting inflammation mediated by COX-2. VW + Chit compared to VW and Chit, confirming significant enhancement of activity in the combined formulation. Numerous studies have documented the anti-inflammatory properties of various natural sources37,38. In line with this, our findings demonstrate that both Chit and VW + Chit formulation possess significant anti-inflammatory potential, effectively inhibiting COX-1 and COX-2 enzyme activity. Notably, the VW + Chit formulation exhibited superior anti-inflammatory effects. These results are consistent with the observations reported by Ghaderi et al.39. Chitosan and its derivatives have gained attention not only for their bioactive properties but also as promising biomaterials for drug delivery systems. The presence of functional groups in their structure allows for the customization of delivery systems with specific characteristics. Notably, chitosan-based systems have also shown potential in preventing inflammation40.
The Table 5 presents the cytotoxic effects of varying concentrations (0 to 1000 µg/mL) of VW, Chit, and VW + Chit on SKOV3 cancer cells. Toxicity is expressed as a percentage of cell death, with statistical significance denoted by superscript letters (a, b, c). At low concentrations (0–62.5 µg/mL), all treatments showed minimal toxicity. VW showed a mild increase in toxicity at 62.5 µg/mL (7.24%), while Chit and VW + Chit remained almost non-toxic. At 125 µg/mL, all treatments demonstrated a significant increase in toxicity, particularly VW + Chit (50.75%), which was slightly more potent than VW or Chit alone. At 250 µg/mL and above, toxicity increased sharply. Chit and VW + Chit exhibited very high toxicity (> 95%), indicating strong cytotoxic potential. VW alone reached 79% toxicity at 250 µg/mL, slightly lower than the other two. The IC₅₀ values—the concentration at which 50% of cells were killed—further highlight the enhanced effect of the combination treatment: VW: 160.8 µg/mL, Chit: 152.24 µg/mL, and VW + Chit: 147.3 µg/mL. This indicates that VW + Chit has the lowest IC₅₀, suggesting it is the most potent formulation against SKOV3 cells. Although the results are not tabulated, inhibition of the WI38 cell line (normal human fetal lung fibroblasts) by VW, Chit, and VW + Chit was observed, but with high IC₅₀ values (318.8 ± 1.33, 310.24 ± 2.66, and 296.3 ± 1.25 µg/mL, respectively), suggesting limited cytotoxicity against normal cells. The statistical differences in IC₅₀ values were also significant (p < 0.05). Moreover, morphological changes were observed in SKOV3 cancer cells with the following order of exposure to VW + Chit, VW, and Chit, respectively depending on their doses (Fig. 5). Cancer of ovary is one of the most prevalent and treatment-resistant cancers among women, often associated with a poor prognosis. Over the past decades, researchers have been striving to develop new strategies to improve treatment outcomes. One of the vaginal wash contents is almond oil, according to Ali et al.41 this oil serves as an effective adjuvant therapy, offering a range of health benefits. Its potential to inhibit tumor angiogenesis is attributed to its rich content of flavonoids, unsaturated fatty acids, polyphenols, and other bioactive compounds. Chitosan-based nanoformulations have been employed for ovarian cancer management, as demonstrated by Alizadeh et al.42. Xu et al.43 developed chitosan nanoparticles loaded with Cinnamomum cassia essential oil (CS-CEO) and evaluated their anticancer efficacy against breast cancer. The formulation remained stable at 4 °C and demonstrated superior in vitro cytotoxicity (IC₅₀ = 52 µg/mL) compared to the free essential oil. The enhanced antitumor activity was associated with increased expression of apoptotic markers Caspase-3 and AIF. In vivo, CS-CEO significantly inhibited the growth of 4T1 breast cancer tumors in mice, reduced cell proliferation, and promoted apoptosis by downregulating Ki-67 expression.
Morphological alterations in SKOV3 cancer cells were observed following treatment with varying concentrations of vaginal wash (VW), chitosan nanoparticles (Chit), and vaginal wash enriched with chitosan nanoparticles (VW + Chit) at doses of 31.25, 62.5, 125, 250, 500, and 1000 µg/mL (1–6, respectively) compared with control cells.
Flow cytometry histograms in representing cell cycle analysis of untreated and treated cells by VW + Chit which stained with propidium iodide (PI) (Fig. 6). These types of plots are typically used to assess the distribution of cells in different phases of the cell cycle was assessed as G0 phase (resting), G1 phase (gap 1), S phase (DNA synthesis), G2/M phase (gap 2/mitosis). G0 phase was 11.93% and 10.44% in treated and untreated cells, respectively indicating more cells possibly entering quiescence. G1 phase was 60.92% and 53.60% in treated and untreated cells, respectively indicating more cells arrested before DNA synthesis while S phase was 21.94% and 4.20% in treated and untreated cells, respectively indicating more cells actively duplicating DNA. Treated cells displays a notable increase in G1 phase arrest, suggesting that more cells are being held before entering the DNA synthesis (S) phase. This typically indicates cell cycle arrest, which is a hallmark of cytotoxic or anti-proliferative activity. In contrast, control shows a significant increase in the S phase population, suggesting that more cells are actively synthesizing DNA, possibly indicating less effective inhibition of proliferation. The greater G0 population in Treated cells supports a shift of cells into a non-proliferative state, reinforcing the idea of stronger growth suppression. Our findings are supported by earlier studies utilizing chitosan nanoparticle-based composites against SKOV3 cells, which demonstrated cell cycle arrest at the S phase44.
Cell cycle analysis of treated SKOV3 cells by VW + Chit showing distribution in G0/G1, S, and G2/M phases compared to untreated cells (control).
Conclusion
The combined analysis of Brett VW and VW + Chit reveals a promising multifunctional formulation with enhanced therapeutic potential. GC-MS analysis detected several compounds in VW for pharmaceutical use. TEM analysis confirms improved nanoparticle dispersion and stability when chitosan is combined with vaginal wash, which likely contributes to the observed boost in biological activity. FTIR results further validate the chemical interaction between Chit and VW, indicating a structurally stable and functionally improved composite. The VW + Chit formulation shows significant synergistic antimicrobial effects, outperforming its individual components and even standard antibiotics, particularly against Gram-positive bacteria and C. albicans, though less effective against M. circinelloides. MIC and MBC/MFC values confirm its enhanced potency across a broad pathogen spectrum. Additionally, VW + Chit demonstrates strong anti-inflammatory activity, especially via COX-2 inhibition, and notable anticancer effects against SKOV3 cancer cells, with lower IC₅₀ values and enhanced cell cycle arrest at the G1 phase. These findings suggest VW + Chit is a potent, broad-spectrum antimicrobial, anti-inflammatory, and anticancer agent. However, further formulation optimization and in vivo studies are needed to confirm its clinical applicability and address remaining efficacy gaps.
Limitations of the study
Despite the promising findings, this investigation has some limitations that must be acknowledged. The investigation was conducted exclusively in vitro, and thus the in vivo biocompatibility, pharmacokinetics, and therapeutic efficacy of the VW + Chit formulation remain unverified. The antimicrobial testing focused on a limited panel of pathogens and did not include multidrug-resistant strains or detailed mechanism-of-action studies. Similarly, while anti-inflammatory and anticancer effects were demonstrated using COX inhibition and SKOV3 cell models, additional mechanistic studies such as apoptosis, ROS generation, were not performed. Lastly, the use of a single cancer cell line (SKOV3) limits generalizability across other ovarian cancer subtypes.
Data availability
The results from the present investigation are available from the corresponding author upon reasonable appeal.
References
Javadi, K., Ferdosi-Shahandashti, E., Rajabnia, M. & Khaledi, M. Vaginal microbiota and gynecological cancers: a complex and evolving relationship. Infect. Agent Cancer 19 (1), 27. https://doi.org/10.1186/s13027-024-00590-7 (2024).
Sobel, J. D. & Vempati, Y. S. Bacterial vaginosis and vulvovaginal candidiasis pathophysiologic interrelationship. Microorganisms 12 (1), 108. https://doi.org/10.3390/microorganisms12010108 (2024).
Facio, F. et al. Infection, inflammation, and sexual function in male and female patients—recommendations from the Fifth International Consultation on Sexual Medicine (ICSM 2024). Sex. Med. Rev. 1, 021 (2025). https://doi.org/10.1093/sxmrev/qeaf021 (2025).
Hillmann, J., Maass, N., Bauerschlag, D. O. & Flörkemeier, I. Promising new drugs and therapeutic approaches for treatment of ovarian cancer-targeting the hallmarks of cancer. BMC Med. 23 (1), 10. https://doi.org/10.1186/s12916-024-03826-w (2025).
Rael, C. T. et al. Understanding women’s vaginal douching behaviors and practices for consideration in the development of a potential future vaginal microbicide douche for HIV prevention: A systematic review of the literature. AIDS Behav. 25 (9), 2992–3010. https://doi.org/10.1007/s10461-021-03290-0 (2021).
Abdelghany, T. M. Stachybotrys chartarum: a novel biological agent for the extracellular synthesis of silver nanoparticles and their antimicrobial activity. Indones J. Biotechnol. 18 (2), 75–82 (2013).
Al-Rajhi, A. M., Salem, S. S., Alharbi, A. A. & Abdelghany, T. M. Ecofriendly synthesis of silver nanoparticles using Kei-apple (Dovyalis caffra) fruit and their efficacy against cancer cells and clinical pathogenic microorganisms. Arab. J. Chem. 15 (7), 103927. https://doi.org/10.1016/j.arabjc (2022).
Alghonaim, M. I., Alsalamah, S. A., Mohammad, A. M. & Abdelghany, T. M. Green synthesis of bimetallic Se@TiO2NPs and their formulation into biopolymers and their utilization as antimicrobial, anti-diabetic, antioxidant, and healing agent in vitro. Biomass Convers. Bioref. 15, 6767–6779. https://doi.org/10.1007/s13399-024-05451-2 (2025).
Abdelghany, T. M. et al. Recent advances in green synthesis of silver nanoparticles and their applications: about future directions. A review. BioNanoSci 8, 5–16. https://doi.org/10.1007/s12668-017-0413-3 (2018).
Abdelghany, T. M. et al. Green fabrication of nanocomposite doped with selenium nanoparticle–based starch and glycogen with its therapeutic activity: antimicrobial, antioxidant, and anti-inflammatory in vitro. Biomass Conv Bioref. 13, 445. https://doi.org/10.1007/s13399-022-03301-7 (2023).
Yahya, R. et al. Molecular Docking and efficacy of Aloe Vera gel based on Chitosan nanoparticles against Helicobacter pylori and its antioxidant and anti-inflammatory activities. Polymers 14, 2994. https://doi.org/10.3390/polym14152994 (2022).
Al-Rajhi, A. M. H. et al. Synthesis of chitosan/Fe2O3/CuO-nanocomposite and their role as inhibitor for some biological disorders in vitro with molecular Docking interactions studies. Int. J. Biol. Macromol. 280 (Pt 1), 135664. https://doi.org/10.1016/j.ijbiomac.2024.135664 (2024).
Selim, S. et al. Biosynthesis and activity of Zn-MnO nanocomposite in vitro with molecular Docking studies against multidrug resistance bacteria and inflammatory activators. Sci. Rep. 15, 2032. https://doi.org/10.1038/s41598-024-85005-8 (2025).
Al Abboud, M. A. et al. Green biosynthesis of bimetallic ZnO@AuNPs with its formulation into cellulose derivative: biological and environmental applications. Bioresour Bioprocess. 11 (1), 60. https://doi.org/10.1186/s40643-024-00759-3 (2024).
Saied, M., Hasanin, M., Abdelghany, T. M., Amin, B. H. & Hashem, A. H. Anticandidal activity of nanocomposite based on nanochitosan, nanostarch and mycosynthesized copper oxide nanoparticles against multidrug-resistant Candida. Int. J. Biol. Macromol. 242, 124709 (2023).
Alsolami, A. et al. Ecofriendly fabrication of natural Jojoba nanoemulsion and chitosan/jojoba nanoemulsion with studying the antimicrobial, anti-biofilm, and anti-diabetic activities in vitro. Biomass Convers. Bioref. 15, 1283–1294. https://doi.org/10.1007/s13399-023-05162-0 (2025).
Alsalamah, S. A., Alghonaim, M. I., Alhejely, A., Alshammari, A. N. & Alfattah, M. A. Biological activities of Quinoa seeds extract and their effects on antioxidants of cancer cells and ultrastructure of Candida tropicalis. BioResources 20 (2), 3612–3627. https://doi.org/10.15376/biores.20.2.3612-3627 (2025).
Rossi, S. et al. Chitosan ascorbate nanoparticles for the vaginal delivery of antibiotic drugs in atrophic vaginitis. Mar. Drugs. 15 (10), 319. https://doi.org/10.3390/md15100319 (2017).
Al-Rajhi, A. M. et al. The green approach of chitosan/Fe2O3/ZnO-nanocomposite synthesis with an evaluation of its biological activities. Appl. Biol. Chem. 67 (1), 75. https://doi.org/10.1186/s13765-024-00926-2 (2024b).
Qanash, H. et al. Phytochemical characterization and efficacy of Artemisia judaica extract loaded Chitosan nanoparticles as inhibitors of cancer proliferation and microbial growth. Polymers 15, 391. https://doi.org/10.3390/polym15020391 (2023).
French, G. L. Bactericidal agents in the treatment of MRSA infections—the potential role of daptomycin. J. Antimicrob. Chemother. 58, 1107 (2006).
Alsalamah, S. A. et al. Effect of UV-C radiation on chemical profile and pharmaceutical application in vitro of Aloe Vera oil. AMB Expr. 15, 83. https://doi.org/10.1186/s13568-025-01884-8 (2025).
Alaa, A. M. et al. Synthesis, anti-inflammatory, analgesic and COX-1/2 Inhibition activities of anilides based on 5, 5-diphenylimidazolidine-2, 4-dione scaffold: molecular Docking studies. Eur. J. Med. Chem. 115, 121–131. https://doi.org/10.1016/j.ejmech.2016.03.011 (2016).
Al-Rajhi, A. M. H. & Abdelghany, T. M. In vitro repress of breast cancer by bio-product of edible Pleurotus ostreatus loaded with Chitosan nanoparticles. Appl. Biol. Chem. 66, 33. https://doi.org/10.1186/s13765-023-00788-0 (2023).
Ligasová, A., Frydrych, I. & Koberna, K. Basic methods of cell cycle analysis. Int. J. Mol. Sci. 24 (4), 3674. https://doi.org/10.3390/ijms24043674 (2023).
Singh, H. Recent development of novel drug delivery of herbal drugs. RPS Pharm. Pharmacol. Rep. 2 (4), 028. https://doi.org/10.1093/rpsppr/rqad028 (2023).
Malik, P. & Upadhyay, P. GC-MS chemical profile, antioxidant activity, and sun protection factor of essential oil of tea tree (Melaleuca alternifolia) and Rosemary (Rosmarinus officinalis L). Orient. J. Chem. 38 (5), 1266–1275. https://doi.org/10.13005/ojc/380524 (2022).
Nayak, R., Kar, B., Ghosh, G. & Rath, G. Current trends in Chitosan based nanopharmaceuticals for topical vaginal therapies. Int. J. Biol. Macromol. 193, 2140–2152. https://doi.org/10.1016/j.ijbiomac.2021.11.045 (2021).
Khan, M. J. et al. Chitosan-doped ZnO nanoparticles for antibacterial, antifungal, and food preservation applications. Global NEST J. 26 (4), 05831. https://doi.org/10.30955/gnj.005831 (2024).
Matussek, F., Pavinatto, A., Knospe, P., Beuermann, S. & Sanfelice, R. C. Controlled release of tea tree oil from a Chitosan matrix containing gold nanoparticles. Polym. (Basel). 14 (18), 3808. https://doi.org/10.3390/polym14183808 (2022).
Oliveira, M. S. et al. Exploring the antimicrobial efficacy of tea tree essential oil and Chitosan against oral pathogens to overcome antimicrobial resistance. Microb. Pathog. 196, 107006. https://doi.org/10.1016/j.micpath.2024.107006 (2024).
de Oliveira, M. S. et al. Poly (ε-caprolactone) nanocapsules coated with Chitosan optimize the antimicrobial activity of tea tree oil and Azithromycin against oral pathogens. Microb. Pathog. 1, 107820. https://doi.org/10.1016/j.micpath.2025.107820 (2025).
Pisseri, F. et al. Antifungal activity of tea tree oil from Melaleuca alternifolia against Trichophyton equinum: an in vivo assay. Phytomedicine 16 (11), 1056–1058. https://doi.org/10.1016/j.phymed.2009.03.013 (2009).
Li, W. R. et al. The dynamics and mechanism of the antimicrobial activity of tea tree oil against bacteria and fungi. Appl. Microbiol. Biotechnol. 100, 8865–8875. https://doi.org/10.1007/s00253-016-7692-4 (2016).
Ibrahim, F. M. et al. Bioactive potential of chitosan–oleic acid nanoparticles loaded with lemon Peel essential oil for topical treatment of vulvovaginal candidiasis. Molecules 29, 5766. https://doi.org/10.3390/molecules29235766 (2024).
Nayak, R. et al. Metronidazole loaded chitosan–phytic acid polyelectrolyte complex nanoparticles as mucoadhesive vaginal delivery system for bacterial vaginosis. Int. J. Biol. Macromol. 255, 128212. https://doi.org/10.1016/j.ijbiomac.2023.128212 (2024).
Alawlaqi, M. M., Al-Rajhi, A. M. H., Abdelghany, T. M., Ganash, M. & Moawad, H. Evaluation of biomedical applications for linseed extract: antimicrobial, antioxidant, anti-diabetic, and anti-inflammatory activities in vitro. J. Funct. Biomaterials. 14 (6), 300. https://doi.org/10.3390/jfb14060300 (2023).
Swidan, K. M., Ismail, M. K. & Abdelghany, T. M. Egyptian citrus honey as a promising antibacterial agent against multidrug-resistant Staphylococcus aureus with anti-oxidant and anti-inflammatory activities. Biol. Biomedical J. 3 (1), 106–116. https://doi.org/10.21608/bbj.2024.344740.1065 (2025).
Ghaderi, G. M., Barzegar, M., Sahari, M. A. & Azizi, M. H. Enhancement of thermal stability and antioxidant activity of thyme essential oil by encapsulation in Chitosan nanoparticles. J. Agric. Sci. Technol. 8, 1781–1792 (2016).
Shi, L., Xu, S., Zhu, Q. & Wei, Y. Chitosan-coated miconazole as an effective anti-inflammatory agent for the treatment of postoperative infections in obstetrics and vaginal yeast infection control on in vitro evaluations. Microb. Pathog. 184, 106312 (2023).
Ali, Z. K. & Sahib, H. B. Antiangiogenic activity of sweet almond (Prunus dulcis) oil alone and in combination with aspirin in both in vivo and in vitro assays. Asian Pac. J. Cancer Prev. 23 (4), 1405–1413. https://doi.org/10.31557/APJCP.2022.23.4.1405 (2022).
Alizadeh, L., Zarebkohan, A., Salehi, R., Ajjoolabady, A. & Rahmati-Yamchi, M. Chitosan-based nanotherapeutics for ovarian cancer treatment. J. Drug Target. 27 (8), 839–852. https://doi.org/10.1080/1061186X.2018.1564923 (2019).
Xu, X. et al. Cinnamon Cassia oil Chitosan nanoparticles: physicochemical properties and anti-breast cancer activity. Int. J. Biol. Macromol. 224, 1065–1078. https://doi.org/10.1016/j.ijbiomac.2022.10.191 (2023).
Chen Yan, Y. M., Chen, Y. & Li, Y. Y. Synthesis of Chitosan oligosaccharide selenium and its antitumor activity. Tradit Med. Res. 9 (10), 56. https://doi.org/10.53388/TMR20240109001 (2024).
Acknowledgements
All authors thank Princess Nourah bint Abdulrahman University Researchers Supporting Project number (PNURSP2025R217), Princess Nourah bint Abdulrahman University, Riyadh, Saudi Arabia.
Funding
Princess Nourah bint Abdulrahman University Researchers Supporting Project number (PNURSP2025R217), Princess Nourah bint Abdulrahman University, Riyadh, Saudi Arabia.
Author information
Authors and Affiliations
Contributions
Methodology and Conceptualization, A.M.H.A., S.A.A. M.H.A. and H.S.G.; Formal analysis and Writing—review and editing, M.T.A., S.M.K., S.S., H.Q., A.S.B and T.M.A.; All authors have read and agreed to the published version of the manuscript.
Corresponding authors
Ethics declarations
Competing interests
The authors declare no competing interests.
Additional information
Publisher’s note
Springer Nature remains neutral with regard to jurisdictional claims in published maps and institutional affiliations.
Rights and permissions
Open Access This article is licensed under a Creative Commons Attribution-NonCommercial-NoDerivatives 4.0 International License, which permits any non-commercial use, sharing, distribution and reproduction in any medium or format, as long as you give appropriate credit to the original author(s) and the source, provide a link to the Creative Commons licence, and indicate if you modified the licensed material. You do not have permission under this licence to share adapted material derived from this article or parts of it. The images or other third party material in this article are included in the article’s Creative Commons licence, unless indicated otherwise in a credit line to the material. If material is not included in the article’s Creative Commons licence and your intended use is not permitted by statutory regulation or exceeds the permitted use, you will need to obtain permission directly from the copyright holder. To view a copy of this licence, visit http://creativecommons.org/licenses/by-nc-nd/4.0/.
About this article
Cite this article
Al-Rajhi, A.M.H., Alsalamah, S.A., Alruhaili, M.H. et al. Innovative vaginal wash formulation with Chitosan nanoparticles targets microbial pathogens, ovarian cancer and inflammation. Sci Rep 15, 41445 (2025). https://doi.org/10.1038/s41598-025-25835-2
Received:
Accepted:
Published:
Version of record:
DOI: https://doi.org/10.1038/s41598-025-25835-2